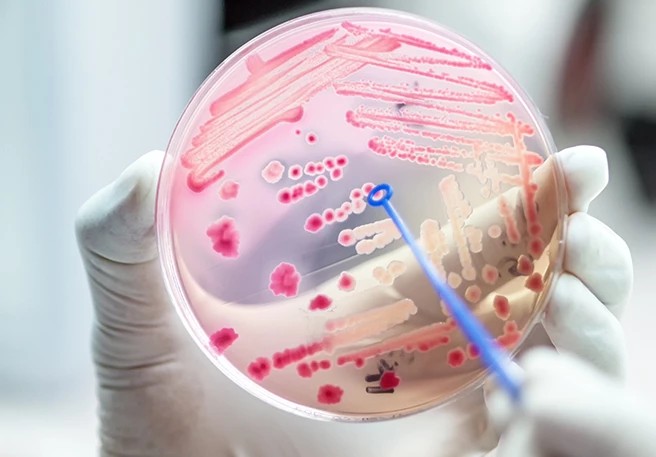

Darm & Immunsystem
Geballte Abwehrkraft gegen Krankheitserreger
Geschätzte Lesedauer: 3.30 Min.
Im Kampf gegen Krankheitskeime und entartete Zellen spielt ein intaktes Immunsystem eine wichtige Rolle. Bekommt dieses natürliche Schutzschild Risse, werden wir für Krankheiten angreifbar. Dagegen sorgt unser Darm für Rückendeckung. Wie genau Darm, Immunsystem und Abwehrkräfte zusammenhängen, erfahren Sie hier.
Wie hängen Darm & Immunsystem zusammen?
Unser Immunsystem soll vor allem eins: Den Körper vor schädlichen inneren und äußeren Einflüssen schützen. Die meisten Menschen wissen nicht, dass unser Immunsystem ein fein abgestimmtes Zusammenspiel verschiedenster biologischer Strukturen und Organe ist, darunter auch dem Darm.

Ist seine Immunfunktion geschwächt, verliert die gesamte körpereigene Abwehr an Stärke und umgekehrt. Somit hat unser Verdauungstrakt maßgeblichen Einfluss auf den Kampf gegen Krankheitsprobierreger und die Gesundheit.
Die verschiedenen Systeme unserer Immunabwehr sind nicht alle von Geburt an funktionstüchtig, sondern entwickeln sich durch Reifungs- und Aktivierungsprozesse. So wird unter anderem sichergestellt, dass das Immunsystem möglichst keine eigenen Strukturen des Körpers angreift.
Kann ein Krankheitserreger die Barrieren überwinden, greifen unspezifische Kompartimente diese Zellen auf und überprüfen sie auf verdächtige Oberflächenstrukturen. Können solche gefunden werden, nehmen Immunzellen sie auf, zerlegen sie und präsentieren die typischen Bruchstücke dem Immunsystem. Passend zu diesen Bruchstücken – medizinisch Antigene – entwickeln spezielle Zellen Antikörper, die in das Blut abgegeben werden. Diese Antikörper heften sich an die im Körper zirkulierenden Krankheitserreger. So markiert, ziehen sie Fresszellen an, die die Keime vernichten.
Der Darm ist unser größtes Immunorgan. Das muss er auch sein, denn mit insgesamt ca. 200 m2 ist er 100mal größer als unsere Körperoberfläche. Diese riesige Fläche wird durch das sogenannte Darm-assoziierte Immunsystem (GALT) kontrolliert. Aufgabe des GALT ist es, Krankheitserreger abzuwehren und gleichzeitig keine Nahrungsbestandteile oder die nützlichen Bakterien der Darmflora anzugreifen. Etwa 90 Prozent aller Antikörper werden im Darm gebildet.
Warum ist die Darmflora fürs Immunsystem wichtig?
Bevor Krankheitserreger überhaupt mit dem Darm-assoziierten Immunsystem in Kontakt kommen, müssen sie eine Barriere überwinden, bei der die Darmschleimhaut und die Darmflora zusammenwirken.
Die Darmflora ist ein individuell zusammengesetztes Gemisch verschiedenster Bakterien und Pilze:
-
Escherischia coli
-
Bifidobakterien
-
Milchsäurebakterien
-
Hefen
Nur einige wenige davon können unter Umständen Krankheiten auslösen, wenn sie an den falschen Ort gelangen. Dies gilt vor allem für die Colibakterien und Hefepilze. Die meisten davon, wie die Bifido- und Milchsäurebakterien, sind nur nützlich und harmlos. Die Aufgaben der Darmflora sind
-
die Verarbeitung von Nahrungsbestandteilen, die unsere eigenen Enzyme nicht bewältigen
-
die Herstellung von Vitaminen
-
die Produktion kurzkettiger Fettsäuren
-
der Abbau von Giften
-
die Produktion kurzkettiger Fettsäuren als Energielieferanten für den Darm
-
die Anregung der Darmbewegung und -funktion
-
mit Krankheitskeimen, um Nahrung und Anheftungsstellen an der Darmschleimhaut zu konkurrieren
-
die Produktion von Stoffen, die das Wachstum anderer Bakterien hemmen.
Welche Bedeutung die Darmflora für die körpereigene Abwehr hat, lässt sich an steril aufgezogenen Labortieren beweisen. Sie beherbergen keine Darmbakterien, zeigen eine deutliche Verkleinerung aller am Immunsystem beteiligten Organe, haben weniger Antikörper im Blut und sind infektanfälliger. Das zeigt, dass eine gesunde Darmflora das Immunsystem unterstützen und uns vor verschiedenen Krankheiten schützen kann.
Das Immunsystem über den Darm beeinflussen
Verschiedene Faktoren üben Einfluss auf das Immunsystem aus. Einige lassen sich über den Darm besonders gut beeinflussen. So spielt die Ernährung eine entscheidende Rolle: Nährstoffe, Vitamine oder Spurenelemente ermöglichen die Erneuerung von zellulären Bestandteilen des Immunsystems und tragen so zu einer normalen Immunabwehr bei.
In dieser Hinsicht kann man die Ernährung gezielt anpassen und über den Darm positiven Einfluss auf das Immunsystem nehmen. Beispielsweise indem man vollwertige Nahrungsmittel und Produkte wie Joghurt oder Kefir zur natürlichen Unterstützung der Abwehr in den täglichen Speiseplan integriert. Sie können die Darmbarriere stärken und die Häufigkeit von Infekten beeinflussen.
Kann der Darm das Immunsystem schwächen?
Ja, weil ein gesunder Darm maßgeblich zu einem intakten Immunsystem beiträgt, ist eine Schwächung der körpereigenen Abwehr durch einen funktionsgestörten Darm ebenso möglich. Gelangen halbverdaute Lebensmittel in den Darm, können sie giftige Zersetzungsprozesse auslösen und auf diese Weise das Immunsystem überfordern. Auch auf psychische Belastungen, wie beispielsweise Stress, reagiert der Darm empfindlich. Stress bereitet unseren Körper auf Kampf und Flucht vor. Bei Stress ziehen sich die Blutgefäße zusammen; um eine bevorzugte Versorgung der Muskeln zu gewährleisten wird besonders der Verdauungstrakt schlechter durchblutet. Dadurch aber werden die Darmzellen mit weniger Sauerstoff und Nährstoffen versorgt, was ihre Funktion auch in Hinsicht auf die Immunabwehr beeinträchtigt.
Umgekehrt kann es bei einer Abwehrschwäche auch zu Verdauungsproblemen kommen. Bei einem nicht intakten Immunsystem können sich Erreger im Darm einnisten und vermehren. Das verschlechtert das Darmmilieu und kann dazu führen, dass wir erkranken.
Tipps für den Darm: Immunsystem stärken
Sie können mit einem gesunden Darm das Immunsystem stärken. Unter anderem können folgende Maßnahmen den Schutz beeinflussen:

-
Achten Sie auf eine gesunde und vielfältige Ernährung
-
Regelmäßige Bewegung hält Verdauung und Immunsystem auf Trab
-
Eine ballaststoffreiche Ernährung fördert die Darmflora
-
Probiotische Lebensmittel können ungewollten Infektionen vorbeugen
-
Schränken Sie Ihren Zuckerkonsum ein
-
Eine Darmsanierung kann das Immunsystem aufbauen
Mit Darmsanierung das Immunsystem unterstützen
Ist Ihre Darmflora stark aus dem Gleichgewicht geraten, reicht eine Ernährungsumstellung allein häufig nicht aus. Von Heilpraktikern wird in solchen Fällen eine Darmsanierung angeraten. Dabei soll der Körper von abgestorbenen Bakterien und schädlichen Substanzen befreit werden. Durch diese Maßnahmen hofft man, die Darmflora positiv zu beeinflussen und auch das Immunsystem zu stärken. Allerdings sind Darmreinigungen durch Einläufe und Spülungen unter Ärzten stark umstritten.
Sinnvoller ist es, den Aufbau der Darmflora mit der gezielten Zufuhr von Bifido- oder Milchsäurebakterien über einen Zeitraum von drei Monaten zu unterstützen. Auf diese Weise wird die Darmflora mit „guten“ Darmbakterien gewissermaßen „aufgeforstet“, was auch eine stärkere Immunabwehr zur Folge haben kann.
Weitere interessante Artikel

Entscheidend für das Wohlbefinden ist ein gesunder Aufbau der Darmflora. Kinder reagieren häufig besonders sensibel auf Darmprobleme.

Mit unseren Ernährungstipps können Sie Ihren Darm im Gleichgewicht halten und für anhaltendes Wohlbefinden sorgen.
Antibiotika greifen im Kampf gegen bakterielle Infektionen auch „gute“ Darmbakterien an. Deswegen sollte die Darmflora begleitend unterstützt werden.

